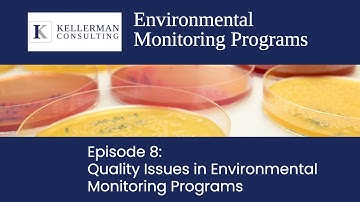
Episode 8: Quality Issues in Environmental Monitoring Programs

⬇ DOWNLOAD NOW
Kalau muncul iklan pop-up, tutup lalu klik tombol kembali
Download lagu Ep 8: Validation and Verification in Quality & Safety Certification Programs | Kellerman Consulting secara gratis hanya untuk keperluan promosi. Dukung artis favorit kamu dengan membeli musik original di iTunes atau platform resmi lainnya.
 Ep. 1: Introduction to Validation & Verification | Kellerman Consulting
Ep. 1: Introduction to Validation & Verification | Kellerman Consulting
 Ep.5: Validation and Verification of Critical Safety and Quality Equipment | Kellerman Consulting
Ep.5: Validation and Verification of Critical Safety and Quality Equipment | Kellerman Consulting
Episode 8: Quality Issues in Environmental Monitoring Programs
Episode 8: Quality Issues in Environmental Monitoring Programs
 Ep. 7: Validation and Verification of Metal Detectors and X-rays | Kellerman Consulting
Ep. 7: Validation and Verification of Metal Detectors and X-rays | Kellerman Consulting
 Ep. 3: Long Term Planning of Validation and Verification | Kellerman Consulting
Ep. 3: Long Term Planning of Validation and Verification | Kellerman Consulting
 Ep.6: Regulatory Requirements & Challenge Studies as part of the Validation and Verification Process
Ep.6: Regulatory Requirements & Challenge Studies as part of the Validation and Verification Process
 Internal Audits Episode 6: Internal Auditing in Quality and Safety Certification Programs
Internal Audits Episode 6: Internal Auditing in Quality and Safety Certification Programs
 Ep. 4: Short Term Planning for Validation and Verification | Kellerman Consulting
Ep. 4: Short Term Planning for Validation and Verification | Kellerman Consulting